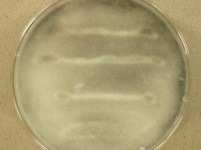

<< back to search
IMAGES:




 OAT tape color.JPG)
 TWA spores.JPG)
TWA tape.JPG)
 TWA tape rhizoid.JPG)
 TWA spores 100x1.JPG)
Search Details
add to cart
| UAMH Number: | 11643 |
|---|---|
| Species Name: | Rhizopus microsporus var. rhizopodiformis |
| Type: | |
| Synonyms: | Mucor rhizopodiformis / Rhizopus cohnii / Rhizopus equinus / Rhizopus pusillus / Rhizopus rhizopodiformis |
| Taxonomy: | FUNGI Mucoromycota, Mucoromycetes, Mucorales, Rhizopodaceae |
| Strain History: | Fuller, J. (MY 1592) -> UAMH |
| Substrate: | swab, ostomy site with necrotic tissue, male 55 yr; calcofluor negative but hyphae seen in histopathology | Location: | CANADA Alberta, Edmonton, University of Alberta Hospitals (GEO: 53.52,-113.523) |
| Isolator: | |
| Isolation Date: | 2012-02-22 |
| Date Received: | 2012-03-07 |
| Characters: | CULTURE CONDITIONS short sporangiophores, finely roughened spores, well developed rhizoids and high temperature tolerance - // MOLECULAR SYSTEMATICS identified as Rhizopus microsporus var. rhizopodiformis based on D1D2 blast result and on phenotypic characteristics - fide UAMH 2012 // THERMOTOLERANT grows at 50, NG at 55C - fide submitting lab (Click for publications citing UAMH 11643) |
| Compounds: | |
| Cross Reference: | MY 1592 |
| Collections: | Living Strains; Dried Herbarium Material |
| Pathogenic Potential: | Human: yes | Animal: yes | Plant: no |
| Biosafety Risk Group: | RG2 (check the PHAC ePATHogen Risk Group Database for updates) |
| Regulatory Requirements: | Canadian requesters must provide PHAC Pathogen and Toxin License Number (see: https://www.canada.ca/en/public-health/services/laboratory-biosafety-biosecurity/licensing-program.html) prior to shipment. International requesters must provide all legally required importation documentation prior to shipment. Plant pathogenicity status may be verified by using the USDA Agricultural Research Service (ARS) Fungal Database |
| MycoBank ID: | 116953 |
IMAGES:



